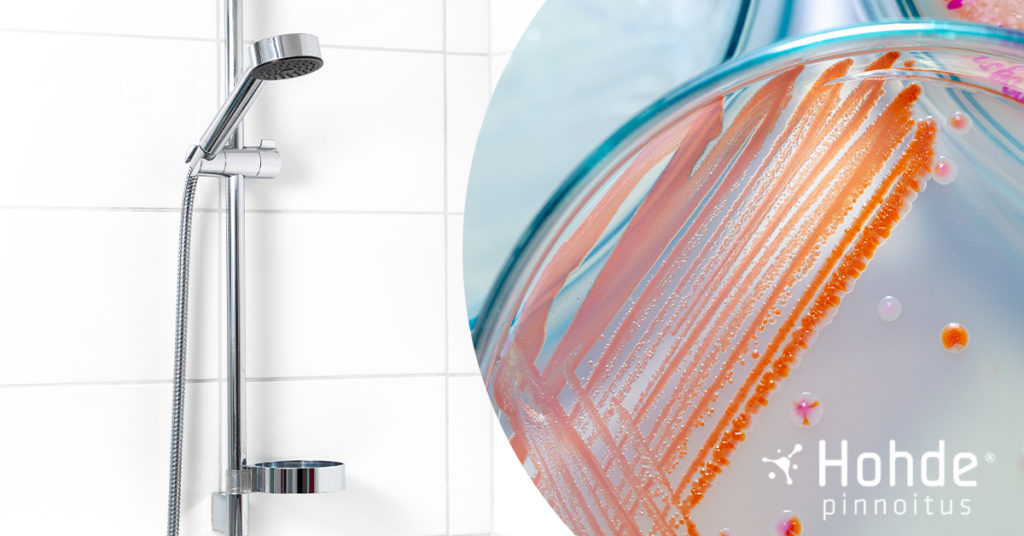

Oletko koskaan miettinyt, miksi silikonisaumoihin ilmestyy mustia pisteitä? Kyseessä on melko yleinen ongelma, joka syntyy, kun kosteus ja orgaaninen aines yhdistyvät, luoden täydelliset olosuhteet mustan homeen kasvulle. Usein kyseessä on Stachybotrys chartarum, joka tunnetaan myös nimellä “mustahome”. Mustahome voi aiheuttaa terveysongelmia, kuten hengitystieoireita ja allergisia reaktioita, erityisesti herkille henkilöille. Jos hometta on verrattain vähän, se […]
Arkisto: mustahome
Homevauriot mietityttävät ja aiheuttavat usein huolta. Home tarvitsee kasvaakseen käytännössä vain vettä, sillä ravinteita on riittävästi ilmassa ja pinnoilla. Kun ilman kosteus materiaalin pinnalla on yli 80 %, mikä tahansa materiaali homehtuu. Tästä syystä homeeseen voi törmätä minkä tahansa materiaalin pinnalla, vaikka usein puuta pidetään homeelle merkittävästi muita materiaaleja alttiimpana. Kylpyhuone saattaa kosteuden vuoksi tarjota […]
Oletko törmännyt kylpyhuoneessasi punaiseen limaan? Värjäytyykö suihkuverhon alaosa vaaleanpunaiseksi, punertaako kylpyhuoneen laattasaumat? Kylpyhuoneessasi on todennäköisesti “punahometta”. Lue oheisesta blogitekstistä parhaat keinot punahomeen poistamiseen ja ennaltaehkäisyyn! Mikä punahome? Suomeksi punahomeen nimi on hieman harhaanjohtava, sillä kyseessä ei ole home laisinkaan. Punahome on todellisuudessa bakteeri, joka kantaa nimeä Serratia marcescens. Kylpyhuone tarjoaa mainiot puitteet punahomeen auvoisalle […]
Oletko harkinnut Hohdepinnoituksen tilaamista? Keräsimme päätöksentekoa helpottamaan ihanien asiakkaidemme kokemuksia ja viisi parasta syytä tilata Hohdepinnoitus. Lue lisää ja pyydä ilmainen hinta-arvio simppelin lomakkeen avulla! Kokemuksia hohdepinnoituksesta Meille on tärkeää, että asiakkaamme saavat kokonaisvaltaisesti hyvää ja yksilöllistä palvelua – alkukartoituksesta aina Hohdepinnoituskäsittelyn viimeiseen työvaiheeseen saakka. Tyytyväinen asiakas on hohtavien pintojen lisäksi tärkein päämäärämme ja samalla […]
Mustahome saa kylpyhuoneen näyttämään epäsiistiltä Mustat pilkut kylpyhuoneen saumoissa tunnetaan usein nimellä mustahome. Mustahome syntyy kosteuden ja huonon ilmanvaihdon seurauksena. Mustahome viihtyykin usein kylpyhuoneen kosteissa nurkissa, silikoni- sekä laattasaumoissa. Puutteellinen ilmanvaihto lisää homeen leviämistä varsinkin silloin, jos tilaa ei kuivata käytön jälkeen kunnolla. Jos hometta on verrattain vähän, se ei yleensä ole merkittävä terveyshaitta, vaan […]